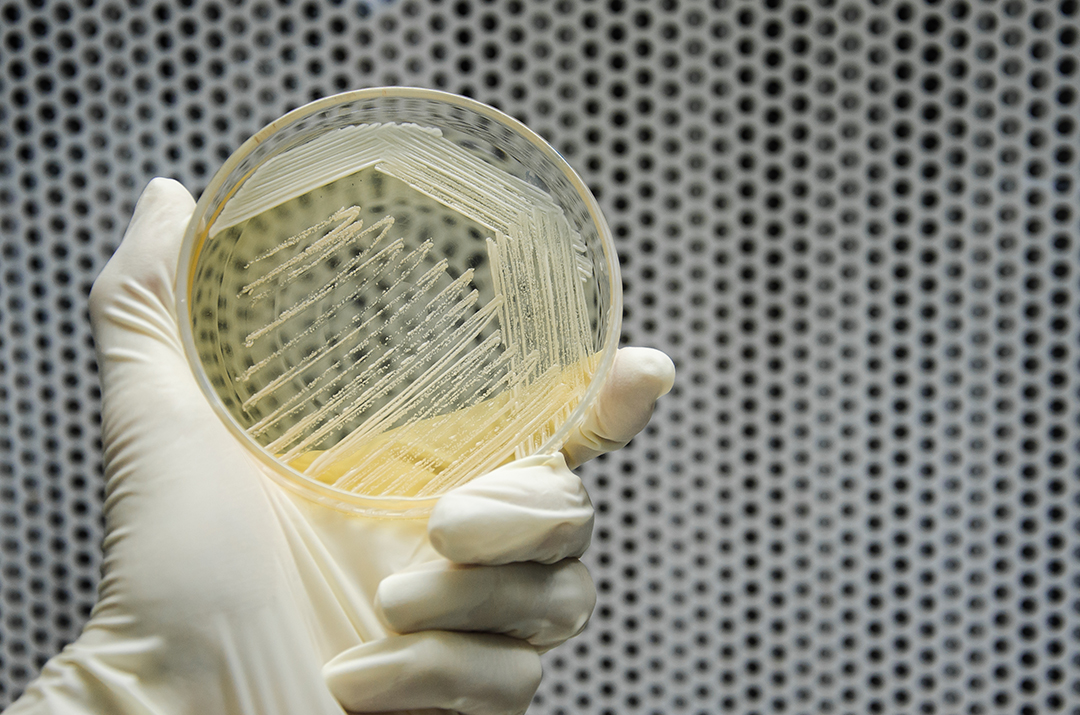

Improving protein synthesis by microfluidic screening and gene downregulation
Protein synthesis is a biotechnical process in which selected genes are inserted into host cells, normally yeast Saccharomyces cerevisiae, that can then produce large amounts of protein. These proteins, called recombinant proteins, can then be used as medicines or enzymes.
The synthesis involves a number of important steps, like the formation of proteins from amino acids, protein folding, transportation, modifications and transport across the cell membrane. During this complex process the proteins interact with a large variety of other cellular processes and alterations to the system might cause a number of malfunctions including cell death.
It is therefore important to find nodes in the cellular machinery that can be re-engineered to optimize protein production, and in the process learn more about how the cellular secretion process in Saccharomyces cerevisiae works.
In a recent study published in PNAS and co-led by Håkan Jönsson (SciLifeLab/KTH), researchers investigated how to downregulate certain genes in order to optimize protein production without disturbing the system. They also established a workflow that will enable yeast strain improvement and shed additional light on the connections between protein production and other cellular processes.
By using RNAi, a method to block expression of certain genes, and microfluidic screening to select cells with improved secretion the researchers managed to identify genes that can all impact the protein production when downregulated.